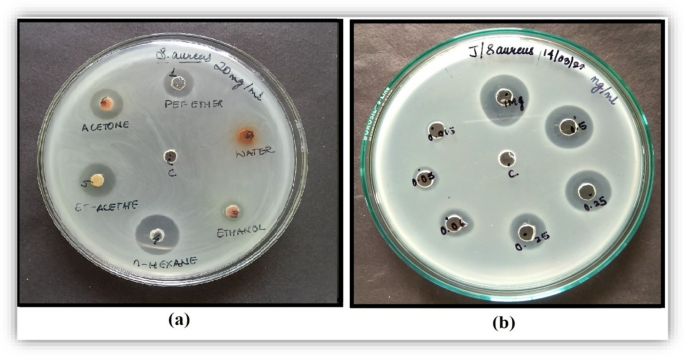
figure 3

- Research
- Open access
- Published:
Qualitative assessment of the flowering buds of Mesua ferrea Linn with special emphasize on HPTLC and universal DNA bar-coding technique and evaluation of its antimicrobial potential
Future Journal of Pharmaceutical Sciences volume 10, Article number: 21 (2024)
Abstract
Background
The study has been scientifically exploring the powder sample and extracts of flowering buds of Mesua ferrea Linn (FBMF) based on pharmacognostic and phytochemical parameters. The medicinal plant Mesua ferrea Linn was identified by Botanical verification and the universal DNA bar-coding technique. The FBMF powder’s quality was performed by the micromeritics properties like bulk density, tapped density, angle of repose, Hausner ratio, Carr’s index, and optical microscopy method, and physicochemical evaluations were performed by the swelling index, foaming index, loss on drying, extractive values, and ash values. The extract’s preliminary phytochemical screening was accomplished by the alkaloids, flavonoids, tannins, steroids, carbohydrates, and glycoside tests. To ensure the presence of a bioactive compound of each FBMF extract by qualitative HPTLC study against the reference β-sitosterol Rf value of 0.83 was revealed at 254 nm with a developed solvent system toluene, ethyl acetate, and acetic acid (6:2:0.1) v/v. Many pharmacological benefits, including those related to wound healing, nonalcoholic fatty liver disease, analgesic, sedative effects, immunomodulatory, anticancer, antimicrobial, anti-inflammatory, anxiolytic, and atopic dermatitis, have been demonstrated by this phytosterol. An antimicrobial study was carried out by a well diffusion method and, lastly, measured minimum inhibitory concentration and compared to the marketed active pharmaceutical component. Numerous skin infections of more invasive, serious illnesses are caused by potential antimicrobial activity.
Results
The universal DNA bar-coding of plant Mesua ferrea Linn has shown a high percentage of identity. The micrometrics properties and physicochemical evaluation of the powder sample of FBMF were in an acceptable range. The preliminary phytochemical screening shows that all extracts contain steroids and carbohydrates. Moreover, flavonoids were found in ethyl acetate and ethanol, and a qualitative HPTLC study confirmed that every extract contains β-sitosterol. N-hexane extract of FBMF shows the potential antimicrobial activity with Staphylococcus aureus, and the MIC value was observed at 0.062 mg/ml.
Conclusion
Our research demonstrated that the plant Mesua ferrea Linn has been successfully authenticated by a DNA bar-coding technique, and all extracts of FBMF contain β-sitosterol. The n-hexane solvent extracts have shown the potential highest antimicrobial effects compared to other extracts. These results support using n-hexane extracts as a traditional medicine for treating several diseases.
Graphical Abstract

Background
Herbal medicinal plants have been used since the prehistoric period for different human diseases and to save people’s lives. They have played an essential role in world health [1, 2]. The herbal plant’s phytoconstituent’s antimicrobial activity is a necessary basis for new pharmacological agents because of antibiotic resistance [3], and it is also a universal problem to be solved through the development of new drugs and discovering new components from different parts of herbal plants in the other solvent extracts[4].
Mesua ferrea Linn, commonly known as Nagakesara in India, is a medium as well as a large-sized tree that can reach about 20–30 m tall, with extremely hard wood, and is used as a stimulant, diaphoretic, and brain tonic. This medicinal plant is also a part of Ayurvedic immunity-boosting remedies like Chyawanprash and Brahma Rasayan. The plant is distributed in several parts of the world, such as Vietnam, Thailand, Sri Lanka, Myanmar, Nepal, Malaysia, China, Cambodia, Bangladesh, and in India like Uttar Pradesh, Tamil Nadu, Sikkim, Odisha, Maharashtra, Kerala, Karnataka, Bihar, Andaman & Nicobar Islands, Assam, and West Bengal. This plant’s flowers are complete and bisexual with functional female (gynoecium) and male (androecium) as well as ovary and carpels, stamens, and sometimes polygamous (male and bisexual). The buds are globular 2 mm diagonally, and scales are in axillary buds. This herbal plant’s flowering and fruiting times are January to March and April to October [5, 6].
A genetic marker is a nucleotide sequence or gene sequence scheduled on a chromosome that is prospective to different species and differentiates cells. Using spurious and adulteration materials as substitutes significantly impairs user safety and efficacy. The DNA sequences are particular and identified with the help of a known molecular marker to detect the exacting sequence of DNA from an unknown group. This is a suitable approach to identifying herbal plant varieties or populations and some species accurately, rapidly, and effectively [7,8,9].
The HPTLC, a very sophisticated instrumental technique, is found to be simple, accurate, and rapid for confirmation of medicinal plant material. It has advantageous features, easily separates the multiplex samples, and is an excellent qualitative and quantitative analysis technique. The comprehensive qualitative advance for evaluation of quality, consistency, species authentication, and stability of herbal drugs, and easily differentiated with digital scanning profile [10, 11]. This high-speed and inexpensive technique requires a minute sample to analyze the reproducible results [12]. The HPTLC technique is essential in plant analysis, as a quick judgment of column fractions, detection of plant material, screening for the content of markers, and development of solvent mixture, which is used for column chromatography. The ability to exhibit chromatograms of many samples as an image may be visually assessed or further processed by specific software. This technique is undoubtedly the most striking benefit of HPTLC and one of its fastest-developing application areas. The images of the same plate can be captured before, during, or after derivatization with various illumination modes [13, 14].
The current study is to perform preliminary studies of powder samples and the low polar to high polar solvent extracts of Mesua ferrea Linn flowering buds. These studies involve micrometric properties and physicochemical evaluations of the powder sample with six solvent extracts, preliminary phytochemical screening, and a qualitative HPTLC study for confirmation of phytoconstituents with the standards of β-sitosterol, and finally, perform an in vitro antimicrobial study of n-hexane extract with well diffusion method. This medicinal plant can prevent the diseases caused by gram-positive bacteria and substitute several diseases that β-sitosterol prevented and is used as a traditional medicine and prepares a novel drug delivery system.
Methods
Collection and identification
Flowering buds of Mesua ferrea Linn. (FBMF) were collected in March 2021 from West Bengal and authenticated of the plant through Griffin’s Herbarium (voucher specimen no. Calophylla.2021/1). The FBMF was picked and removed all dust and sand very carefully. Cleaned flowering buds were cut into tiny pieces and shade-dried. After eight weeks, bud pieces were utterly dried and pulverized into powder form by the grinder (Nano Mixture Grinder MX 116) and, finally, sized reduction through a 60-number mass sieve.
Genotypic identification
The quality of the DNA isolate was examined by using agarose gel electrophoresis. One microliter of 6X gel-loading buffer [30% sucrose in TE buffer (pH-8.0), bromophenol blue (0.25%)] was added to five microliters of DNA. The prepared samples were loaded with 0.8% agarose gel ready to 0.5X Tris–Borate-EDTA buffers containing 0.5 µg/ml of ethidium bromide. Electrophoresis was performed by 0.5X TBE (Tris/Borate/EDTA) as an electrophoresis buffer (75 V) until the bromophenol dye front migrated toward the base of the gel. The gels were observed in a UV transilluminator (Genei), and finally, the image was captured under UV light with a Gel documentation system (Bio-Rad) [8, 15]. This DNA bar-coding method (Universal primers of RBCL) was performed at the Rajiv Gandhi Centre for Biotechnology.
Micromeritic properties
The bulk density of FBMF powder was measured by an accurately weighed (20 g) field to a graduated cylinder, and the bulk volume was noted. The bulk density was calculated by the powder mass divided by the powder volume and tapping a graduated cylinder until the stable volume was observed, and then, the tapped volume was noted. This density was calculated by the powder’s mass divided by the tapped powder volume. The following formula calculated the Hausner ratio and Carr’s index/Hausner ratio = tapped density/bulk density and percentage of Carr’s index = (tapped density − bulk density)/tapped density × 100. The angle of repose was performed to evaluate the flow property of FBMF powders with the help of a vertically fitted funnel. The powder sample was passed through the funnel onto a horizontal surface on graph paper, and powder pile height (h) and base radius (r) were determined. Finally, the angle of repose (θ) was calculated with the help of the (θ) = tan−1(h/r) equation [16].
The optical microscopic method was used to estimate the particle size (0.2 µm to 100 µm) with the help of an ordinary microscope after calibration of the eyepiece micrometer. The crude powder sample (FBMF) was placed on a glass slide and observed through a microscope. The particle diameter (length and breadth) was calculated and recorded in the list of 300 particles. The average particle size was calculated, and recorded data were represented in a size distribution curve [17, 18].
Extraction of FBMF
The FBMF was extracted through slightly modified methods of Oliveira et al. [19]. Briefly, the FBMF powder was extracted through cold maceration methods at room temperature, according to the low polar solvent to high polar solvents such as n-hexane, petroleum ether, ethyl acetate, acetone, ethanol, and finally with water. The FBMF powders (150 g) were soaked in 400 ml of n-hexane solvent continuously for seven days in a conical flask, and filtration was done with the help of Whatman No.1 filter paper. Then, the marc was dried for 24 h, and again used the marc for the successive solvent. Every filtrate sample was collected in a previously weighted Petri dish, evaporated at 40 °C temperatures through a water bath, kept in desiccators, and transferred into a well-closed container for additional use.
Physicochemical evaluation
The physicochemical parameters of FBMF were determined by the quality control methods, according to the updated edition of World Health Organization 2011 and Farooq et al. methods, such as loss on drying, extractive yield, swelling index, ash values (total ash and acid insoluble ash), and foaming index [20, 21].
Preliminary phytochemical screening
Various classes of phytochemicals on FBMF extracts were detected through the preliminary phytochemical screening. The alkaloid on FBMF was detected by Dragendorff’s, Hager’s, and Wagner’s test, and flavonoids were evaluated by Shinoda’s alkaline reagent and concentrated H2SO4 test. The detection of tannin was performed with the Braymer’s, Gelatin, and NaOH test, and the presence of steroids was detected by the FeCl test. The carbohydrates were detected by Molisch’s, Seliwanoff’s, and Resorcinol tests, and finally, glycoside through Legal’s, NaOH, and Baljet tests [22, 23].
Development of chromatographic profile
Kabra et al. standard HPTLC method was followed to develop a chromatographic profile of various extracts of FBMF [24]. The CAMAG® Linomat 5 (Camag, Muttenz, Switzerland) instrument was used for the chromatographic qualitative method. Each solvent extract of FBMF was developed with the help of a mobile phase that contains toluene, ethyl acetate, and acetic acid (6:2:0.1) v/v to confirm the contingency of various fractions of phytoconstituents. Aluminum plates of TLC Silica gel 60 F254 (Sigma-Aldrich, Invoice No ASM/140/21-22) were used as a stationary phase for chromatographic separation. Standard plant steroids β-sitosterol (Sigma-Aldrich, Invoice No TI/2021-22/1028) and every extract (10 µl) were spotted as bands of length 8.0 mm and width 0.0 mm. The prepared solvent systems were transferred to a developed chamber (CAMAG twin trough plate) for 20 min to develop the plate. Then, the resulting plate was dried at room temperature for five minutes and scanned. The developed spots were scanned with the help of TLC Scanner 4(S/N: 270,741) at wavelength 254 nm. Finally, the Rf (retention factor) value for every spot was measured and recorded with the help of Vision CAT software.
In vitro antimicrobial study
The antimicrobial activities of every FBMF extract were examined using a well diffusion assay against Staphylococcus aureus (gram-positive bacteria) and Pseudomonas aeruginosa (gram-negative bacteria). Briefly, 0.8% of agar was mixed with approximately 24 h of the Pseudomonas aeruginosa 1688 and Staphylococcus aureus MTCCS96 indicator standard strains and overlaid on a Petri plate containing a bottom with 1.5% of nutrient agar and allowed to solidify. The solvent was prepared by the 9:1 water ratio along with dimethyl sulfoxide and mixed with every extract. Five millimeters in diameter wells were perforated, and 100 μl of the prepared sample extract of FBMF was placed into each well. The agar plates were prepared at room temperature and incubated at 37 °C for 18–24 h. The antimicrobial activities of the samples were determined by measuring the diameters of the inhibition zones. Inhibition was recorded as negative if no zone was observed around the agar well, and the prepared solvent was kept as a control against each extract of FBMF. For MIC, different concentrations of the sample were prepared using prepared solvent, and the minimum concentration zone of inhibition was recorded through plate assay followed by broth microdilution method through the guidelines of the CLSI (Clinical and Laboratory Standards Institute). Every extract sample was dissolved in the prepared solvent and diluted in nutrient broth in a range of (0.015–1) mg/ml [25, 26]. We performed the antimicrobial activity against standard streptomycin (active pharmaceutical ingredients) for better results.
Results
Identification of plant
The polymerase chain reaction (PCR) amplification was accomplished with universal primers RBCL-AF forward primer sequence (5’-TGTCACCACAAACAGAGACTAAAGC-3’) A and RBCL-724R reverse primer (5’-TCGCATGTACCTGCAGTAGC-3’) within a PCR thermal cycler (GeneAmp PCR System 9700, Applied Biosystems). This medicinal plant was given a high percentage of identity.
Micromeritic properties
The micromeritic properties such as bulk density, tapped density, Carr’s index and Hausner ratio, angle of repose, and optical microscopic of the FBMF powder are represented in Table 1. The frequency distribution curves (histogram) of the optical microscopic method and the powder sample microscopic views are expressed in Fig. 1.
Physicochemical evaluation
The obtained results of swelling factor, foaming index, total ash value, acid insoluble ash, moisture content of powder sample, and extractive yield of different solvent extracts of FBMF are represented in Table 1.
Preliminary phytochemical screening
Phytochemical screening of the extract’s active constituents was detected by a minimum of three tests (without steroids), such as alkaloids, flavonoids, tannins, carbohydrates, and glycosides which are reported in Table 2.
Development of chromatographic profile
The qualitative HPTLC analysis of every extract of FBMF was carried out against standard phytosterol β-sitosterol using a solvent system of toluene/ethyl acetate/acetic acid (6:2:0.1) for assurance of bioactive compounds. The β-sitosterol Rf value of 0.83 was revealed at 254 nm, and these were compared to six extracts of FBMFs. The maximum Rf values of each reading were recorded and are shown in Fig. 2.
In vitro antimicrobial study
The gram-positive strain, Staphylococcus aureus, showed antimicrobial activity through FBMF extracts (except water extract), and gram-negative stains, Pseudomonas aeruginosa, did not show any activity. The highest MIC value was observed in n-hexane extracts, and the lowest or no activity was produced in the water extracts against S. aureus. Antibacterial assay of n-hexane extract sample with various concentrations was measured against S. aureus S96, and the highest zone of inhibition was observed at 0.062 mg/ml, as shown in Table 3 and Fig. 3. The antimicrobial activity against standard streptomycin (0.062 mg/ml) against S. aureus shows 14 mm, and the sample (n-hexane extract) shows 13 mm. The MIC values were determined as the lowest concentrations and inhibited bacterial growth by 80% compared to the agent-free growth control.
Discussion
The World Health Organization suggests accurately identifying plant species for the safety, efficacy, and quality of herbal medicine. Conventional identification methods need an adequate perspective to differentiate the closely related species of the same genus of medicinal plant species. DNA international bar-coding genetic tools have been developed to identify herbal medicine [27]. This Mesua ferrea Linn medicinal plant was authenticated by two methods such as conventional (botanical verification) as well as a universal barcode (DNA bar-coding technique).
The powder sample bulk density depends upon the particle shape, the tendency of the particles, and particle size distribution. The tapped density influences the compaction profile and packing arrangement of materials and describes the particle’s void space [17]. The bulk density and tapped density of the FBMF powder sample were 0.39 g/cc and 0.54 g/cc. The angle of repose, Carr’s index, and Hausner ratio values represent the flow of the powder sample. The angle of repose is also associated with the bulk density, tapped density, and Hausner ratio of the powder sample. The flow properties of the normal powder sample values are a fair range of 16–20 (Carr’s index), a passable range of 1.26–1.34 (Hausner ratio), and free-flowing range of 30°–38° (angle of repose) [28, 29]. The FBMF powder sample’s Hausner ratio, Carr’s index, and angle of repose were found to be in a passable range of 1.22, fair range of 18.12, and free-flowing range of 36.90°, respectively. Moreover, all the studies were obtained by three observations with the help of standard deviation (SD) and standard error of the mean (SEM) for better results. The particle size distribution and particle size of the powder sample also impacted the flow property of the powder [30]. In this study, the FBMF sample arithmetic means and volume surface means were found to be 34.17 µm and 48.66 µm.
The physicochemical characteristics of crude herbal medications provide the most incredible support for standardization and quality control. The presence of hemicelluloses or pectin and mucilage in crude materials is determined in a swelling index, and the foaming index is performed only in saponin-containing plants that generate swelling in an aqueous medium. The presence of water and volatile matter in the powder samples has been calculated by the loss on drying methods for preservation purposes such as the growth of molds or yeasts. Physiological and nonphysiological ash has been determined after the incineration of crude materials by the total ash value methods, and the earthy material, as well as the number of silica contaminants, is measured by the acid insoluble ash methods [20, 21]. In our studies, visible foreign matters were free from more significant parts of the powder sample of FBMF. This plant’s swelling index and foaming index were observed to be 8.10 ml, and the foaming index was over 1000 (1.4 cm). In this plant sample, the percentage of moisture content was found to be 1.40%, indicating within the range’s limits. The total ash value of 3.67% and no acid insoluble ash were present in this plant, which is an acceptable range and indicate no earth and silica material are present. The extractive yield of the powder sample of FBMF was observed by the cold maceration methods with six solvents (low polar to high polar). The result revealed that the percentage of extractive yield was highest in water extract (3.9%) compared to the other five solvents.
In previous research, phytochemical screening of this plant was performed with only two extracts (aqueous and ethanol). Phytochemicals such as coumarins, saponins, phenols, and flavonoids were present in aqueous extracts, and coumarins, saponins, flavonoids, phenols, and sterols in ethanol extract [31]. The present study performed the phytochemical constituents in six solvent extracts. Every extract showed the presence of steroids and carbohydrates. Chemical components such as alkaloids, tannins, and glycosides are absent in FBMF extracts. The flavonoids were found to be in ethyl acetate and ethanol. The acetone and water extract also showed flavonoids in the alkaline reagent and Shinoda tests, respectively.
Huge populations of the world are used herbal medicine for their health needs. However, still very challenging for quality assurance and quality control of herbal drugs because of elevated unevenness mixed up phytochemicals [32]. Analytical separation techniques such as HPTLC methods have very potent tools for herbal formulation and very accepted methods for quality control of herbal raw materials and the finished product [33]. In a previous research study, Chow et al. showed that the heartwood part of Mesua ferrea L contains β-sitosterol [34]. Teh et al. and Ee et al. both research teams isolated β-sitosterol from this herbal plant’s root bark extracts [35, 36], and Keawsa-Ard et al. research studies also isolated phytosteroid from the plant stem parts of hexane extract [37]. Our study found phytosterols β-sitosterol in every extract based on our identification of HPTLC qualitative studies. The β-sitosterol bioactive compounds are present in many herbal plant cell membranes. This phytosterol has shown a variety of biological actions in in vitro as well as in vivo studies, such as anti-diabetic, wound healing, nonalcoholic fatty liver disease, anticancer, analgesic, antimicrobial, immunomodulatory, anti-inflammatory, anxiolytic, sedative effects [38], and atopic dermatitis [39].
Keawsa-Ard et al.’s research showed stems of M. ferrea had moderately antibacterial activity against E. coli and Staphylococcus aureus [37]. The current investigation demonstrated greater effectiveness against S. aureus in n-hexane extracts of FBMF, and when compared with the marketed standard, these show a slightly lesser effect. This gram-positive strain is the most infamous and widespread bacterial pathogen, and it is responsible for a significant number of skin infections and hundreds of thousands to millions of more invasive severe infections. It contributes significantly to the emergence of prosthetic joints, surgical sites, cardiovascular infections, respiratory tract infections, and pneumonia [40, 41], and this bacterium has been observed in ninety percent of atopic dermatitis skin lesions, and the density of this gram-positive bacterium tends to raise the severity [42].
Conclusion
The conclusion indicates that the medicinal plant of Mesua ferrea Linn has been successfully authenticated through a DNA bar-coding technique and Botanical verification. The FBMF powder’s characteristics produced satisfactory results. The preliminary phytochemical screening reveals that the extracts with plant steroids and carbohydrates are present in low polar to high polar solvents extract. The HPTLC qualitative study confirms that every extract of FBMF contains β-sitosterol. The n-hexane solvent extract showed better antimicrobial activity compared to the other extracts. This primary evidence can trigger a potential substitute in various diseases that were prevented by the β-sitosterol (analgesic, anti-inflammatory, anti-diabetic, sedative effects, wound healing, liver disease, anticancer, antimicrobial, atopic dermatitis, immunomodulatory, and anxiolytic) and the disease produced by the gram-positive bacteria S. aureus (large quantity of skin infections) can be prevented by this medicinal plant and is also used as traditional medicine as well as a novel herbal drug delivery system.
Availability of data and material
Data to support the findings of this study are available from the corresponding author and also the first author upon reasonable request.
Abbreviations
- FBMF:
-
Flowering buds of Mesua ferrea Linn
- HPTLC:
-
High-performance thin layer chromatography
- TLC:
-
Thin layer chromatography
- PCR:
-
Polymerase chain reaction
- CLSI:
-
Clinical and Laboratory Standards Institute
- MIC:
-
Minimum inhibitory concentration
- S. aureus :
-
Staphylococcus aureus
- SD:
-
Standard deviation
- SEM:
-
Standard error of mean
References
Zhang X, Gao R, Liu Y, Cong Y, Zhang D, Zhang Y, Yang X, Lu C (2019) Anti-virulence activities of biflavonoids from Mesua ferrea L. flower. Drug Discov Ther 13(4):222–227
Kumar KS, Pushpendra P, Holla BS, Ravishankar B, Yashovarma B (2015) High performance thin layer chromatography qualitative densitometry as a sensitive method to assess shelf life of polyherbal formulations: a study on Hutabhugadi Churna. Ayu 36(3):303–310. https://doi.org/10.4103/0974-8520.182745
Zhang XC, Yang XF, Gu TZ, Cao YF, Lu CH (2020) Anti-microbial polycyclic polyprenylated acylphoroglucinols from Mesua ferrea flower. Phytochem Lett 40:84–88
Bagheri G, Ayatollahi SA, Ramírez-Alarcón K, Salehi B, Mohammadi R, Rahmani A, Martorell M, Sharifi-Rad J, Sheibani M, Amarowicz R (2020) Phytochemical screening of Alstonia venenata leaf and bark extracts and their anti-microbial activities. Cell Mol Biol 66(4):224–231
India Biodiversity Portal (Mesua ferrea L.)https://indiabiodiversity.org/species/show/15613. Accessed 12 May 2023
Shirsat P, AR Z, Kashikar R, Athavale M, Athavale T, Taware P, Saldanha T, Kolhe S, Tembhurne S (2022) Subacute toxicity study of the ethanolic extract of Mesua ferrea (L.) flowers in rats. Drug Chem Toxicol 45(4):1570–1577
Ganie SH, Upadhyay P, Das S, Sharma MP (2015) Authentication of medicinal plants by DNA markers. Plant Gene 4:83–99
Techen N, Parveen I, Pan Z, Khan IA (2014) DNA bar-coding of medicinal plant material for identification. Curr Opin Biotechnol 25:103–110
de Vere N, Rich TC, Trinder SA, Long C (2015) DNA bar-coding for plants. Methods Mol Biol 1245:101–118
Chewchinda S, Kongkiatpaiboon S (2020) A validated HPTLC method for quantitative analysis of morin in Maclura cochinchinensis heartwood. Chin Herb Med 12(2):200–203
Srivastava M (ed) (2010) High-performance thin-layer chromatography (HPTLC). Springer, Berlin, Heidelberg. https://doi.org/10.1007/978-3-642-14025-9
Chew YL, Khor MA, Lim YY (2021) Choices of chromatographic methods as stability indicating assays for pharmaceutical products: a review. Heliyon 7(3):e06553
Reich E, Widmer V (2009) Plant analysis 2008–planar chromatography. Planta Med 75(07):711–718
Salomé-Abarca LF, van den Hondel CAMJJ, Erol Ö, Klinkhamer PGL, Kim HK, Choi YH (2021) HPTLC-Based chemical profiling: an approach to monitor plant metabolic expansion caused by fungal endophytes. Metabolites 11:174
Innis MA, Gelfand DH, Sninsky JJ, White TJ (eds) (2012) PCR protocols: a guide to methods and applications. Academic Press, San Diego, CA
Munir A, Youssef FS, Ishtiaq S, Kamran SH, Sirwi A, Ahmed SA, Ashour ML, Elhady SS (2021) Malva parviflora leaves mucilage: an eco-friendly and sustainable biopolymer with antioxidant properties. Polymers 13(23):4251
Sinko PJ, Singh Y (2011) Martin’s Physical Pharmacy and Pharmaceutical Science: Physical Chemical and Biopharmaceutical Principal in the Pharmaceutical Sciences. Martin’s Physical Pharmacy and Pharmaceutical Sciences: Physical Chemical and Biopharmaceutical Principles in the Pharmaceutical Sciences: Sixth (edn). Lippincott Williams & Wilkins, Baltimore, pp 849–863.
Gacem MA, Telli A, Gacem H, Ould-El-Hadj-Khelil A (2019) Phytochemical screening, antifungal and antioxidant activities of three medicinal plants from Algerian steppe and Sahara (preliminary screening studies). SN Appl Sci 1:1–3
Oliveira DA, Angonese M, Gomes C, Ferreira SR (2016) Valorization of passion fruit (Passiflora edulis sp.) by-products: sustainable recovery and biological activities. J Supercrit Fluids 111:55–62
World Health Organization. Quality control methods for herbal materials. https://apps.who.int/iris/handle/10665/44479. Accessed 20 May 2023
Farooq U, Malviya R, Sharma PK (2014) Extraction and characterization of artocarpus integer gum as pharmaceutical excipient. Polim Med 44(2):69–74
Mukherjee PK (2019) Quality control and evaluation of herbal drugs: evaluating natural products and traditional medicine. Elsevier, Amsterdam, The Netherlands
Abubakar AR, Haque M (2020) Preparation of medicinal plants: basic extraction and fractionation procedures for experimental purposes. J Pharm Bioallied Sci 12(1):1–10
Kabra A, Sharma R, Singla S, Kabra R, Baghel US (2019) Pharmacognostic characterization of Myrica esculenta leaves. J Ayurveda Integr Med 10(1):18–24
Singh D, Sharma D, Agarwal V (2021) Screening of anti-microbial, anti-biofilm activity, and cytotoxicity analysis of a designed polyherbal formulation against shigellosis. J Ayurveda Integr Med 12:601–606
Houdkova M, Urbanova K, Doskocil I, Soon JW, Foliga T, Novy P, Kokoska L (2021) Anti-staphylococcal activity, cytotoxicity, and chemical composition of hexane extracts from arils and seeds of two Samoan Myristica spp. S Afr J Bot 139:1–5
Moon BC, Lee YM, Kim WJ, Ji Y, Kang YM, Choi G (2016) Development of molecular markers for authentication of the medicinal plant species Patrinia by random amplified polymorphic DNA (RAPD) analysis and multiplex-PCR. Hortic Environ Biotechnol 57:182–190
Kaleem MA, Alam MZ, Khan M, Jaffery SH, Rashid B (2021) An experimental investigation on accuracy of Hausner Ratio and Carr Index of powders in additive manufacturing processes. Met Powder Rep 76:S50–S54. https://doi.org/10.1016/j.mprp.2020.06.061
Al-Hashemi HM, Al-Amoudi OS (2018) A review on the angle of repose of granular materials. Powder technol 330:397–417
Gohel MC, Jogani PD, Bariya SH (2003) Development of agglomerated directly compressible diluent consisting of brittle and ductile materials. Pharm Dev Technol 8(2):143–151
Rajalakshmi P, Vadivel V, Ravichandran N, Brindha P (2019) Investigation on pharmacognostic parameters of sirunagapoo (Mesua ferrea L): a traditional Indian herbal drug. Pharmacogn J 11(2)
Ekor M (2014) The growing use of herbal medicines: issues relating to adverse reactions and challenges in monitoring safety. Front Pharmacol 4:177
Ram M, Abdin MZ, Khan MA, Jha P (2011) HPTLC fingerprint analysis: a quality control for authentication of herbal phytochemicals. In: Srivastava M (ed) High-performance thin-layer chromatography (HPTLC). Springer, Berlin, Heidelberg. https://doi.org/10.1007/978-3-642-14025-9_7
Chow YL, Quon HH (1968) Chemical constituents of the heartwood of Mesua ferrea. Phytochemistry 7(10):1871–1874
Teh SS, Ee GC, Rahmani M, Taufiq-Yap YH, Go R, Mah SH (2011) Pyranoxanthones from Mesua ferrea. Molecules 16(7):5647–5654
Ee GC, Teh SS, Rahmani M, Taufiq-Yap YH, Go R, Mah SH (2012) A new furanoxanthone from the root bark of Mesua ferrea. Lett Org Chem 9:457–459
Keawsa-Ard S, Liawruangrath B, Kongtaweelert S (2015) Bioactive compounds from Mesua ferrea stems. Chiang Mai J Sci 42(1):185–955
Babu S, Jayaraman S (2020) An update on β-sitosterol: a potential herbal nutraceutical for diabetic management. Biomed Pharmacother 131:110702
Kim SJ (2017) The ameliorative effect of β-sitosterol on DNCB-induced atopic dermatitis in mice. Biomed Sci Lett 23:303–309
Cheung GYC, Bae JS, Otto M (2021) Pathogenicity and virulence of Staphylococcus aureus. Virulence 12(1):547–569
Oliveira D, Borges A, Simões M (2018) Staphylococcus aureus toxins and their molecular activity in infectious diseases. Toxins 10(6):252
Langan SM, Irvine AD, Weidinger S (2020) Atopic dermatitis. Lancet 396:345–360
Acknowledgements
The author thanks Ganesh Dey, Simran Giri, and Divya Limbu for their assistance and support. The authors acknowledge the Department of Pharmaceutical Technology, the University of North Bengal, for the instrumentation facility.
Funding
This study did not receive any funding from an agency or person.
Author information
Authors and Affiliations
Contributions
Jugal Sutradhar contributed to writing—original draft preparation, and methodology and provided software; Bapi Ray Sarkar supervised and analyzed the data, investigation, visualization, reviewing, and editing.
Corresponding author
Ethics declarations
Ethics approval and consent to participate
No human or animal subjects were involved in the study.
Consent for publication
There is no conflict of interest.
Competing interests
The authors state that they are not competing interests.
Additional information
Publisher's Note
Springer Nature remains neutral with regard to jurisdictional claims in published maps and institutional affiliations.
Rights and permissions
Open Access This article is licensed under a Creative Commons Attribution 4.0 International License, which permits use, sharing, adaptation, distribution and reproduction in any medium or format, as long as you give appropriate credit to the original author(s) and the source, provide a link to the Creative Commons licence, and indicate if changes were made. The images or other third party material in this article are included in the article's Creative Commons licence, unless indicated otherwise in a credit line to the material. If material is not included in the article's Creative Commons licence and your intended use is not permitted by statutory regulation or exceeds the permitted use, you will need to obtain permission directly from the copyright holder. To view a copy of this licence, visit http://creativecommons.org/licenses/by/4.0/.
About this article
Cite this article
Sutradhar, J., Sarkar, B.R. Qualitative assessment of the flowering buds of Mesua ferrea Linn with special emphasize on HPTLC and universal DNA bar-coding technique and evaluation of its antimicrobial potential. Futur J Pharm Sci 10, 21 (2024). https://doi.org/10.1186/s43094-024-00596-3
Received:
Accepted:
Published:
DOI: https://doi.org/10.1186/s43094-024-00596-3